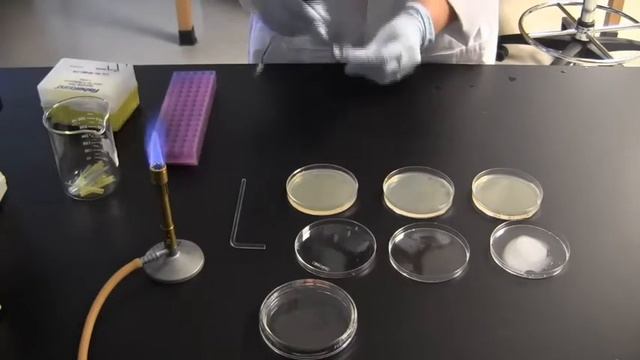
SUR Techniques Clip: Plating

Лесные мелодии и пение птиц природы
- ⌚ 03.02.2025 36 - это много или мало?
- ⌚ 03.02.2025 A.a Seimo Narys Julius Veselka Apie Landsbergizmą
- ⌚ 03.02.2025 ЦРД "Веселка" ЗМР Ігри для профілактики плоскостопості
- ⌚ 03.02.2025 Blender: Cage; Panopticon MMA For RIZIN GP VTR
- ⌚ 03.02.2025 МУКБАНГ
- ⌚ 03.02.2025 нож мухомор ч1
- ⌚ 03.02.2025 2 группа РАДУГА Тема У ВЕЧНОГО ОГНЯ
- ⌚ 03.02.2025 2 Ingredient Chocolate Truffles! Two Ingredient Takeover Holiday Recipes!
- ⌚ 03.02.2025 ԽՈԶԻ ՄԻՍԸ ԵՎ ԿԱՐՏՈՖԻԼԸ ՀԱՏՈՒԿ ՍՈՈՒՍՈՎ
- ⌚ 03.02.2025 Грибы и голем #3-12 подвигов Геракла 6. Гонка за Олимп
- ⌚ 03.02.2025 [РБ] Гриб в корзинке 10.06.20 (PWClassic 1.3.6)
- ⌚ 03.02.2025 SUR Techniques Clip: Plating
- ⌚ 03.02.2025 Snow Fungus -Found Rare Jelly Fungi While Foraging!
- ⌚ 03.02.2025 Видео с нашего второго канала
- ⌚ 03.02.2025 Tofu In Black Bean Sauce ( VEGAN )- Episode 946
- ⌚ 03.02.2025 Слепящее солнце и 1ая строчка в эвенте WRC9
- ⌚ 03.02.2025 Православний Вісник №167 | від 17 липня 2016 р.
- ⌚ 03.02.2025 Көгалдандыру
- ⌚ 03.02.2025 Здоровье мудрых гонорар! Этот фильм изменит Вашу жизнь!
- ⌚ 03.02.2025 How To Make Cake-Pops!! 🍰 • CookingVibesWithVivi • Intro And Outro Coming Out Soon! 🥰











![[РБ] Гриб в корзинке 10.06.20 (PWClassic 1.3.6)](http://pic.rtbcdn.ru/video/2025-02-03/05/a9/05a9a75c5bae838a4c316f1afda6fc9a.jpg)